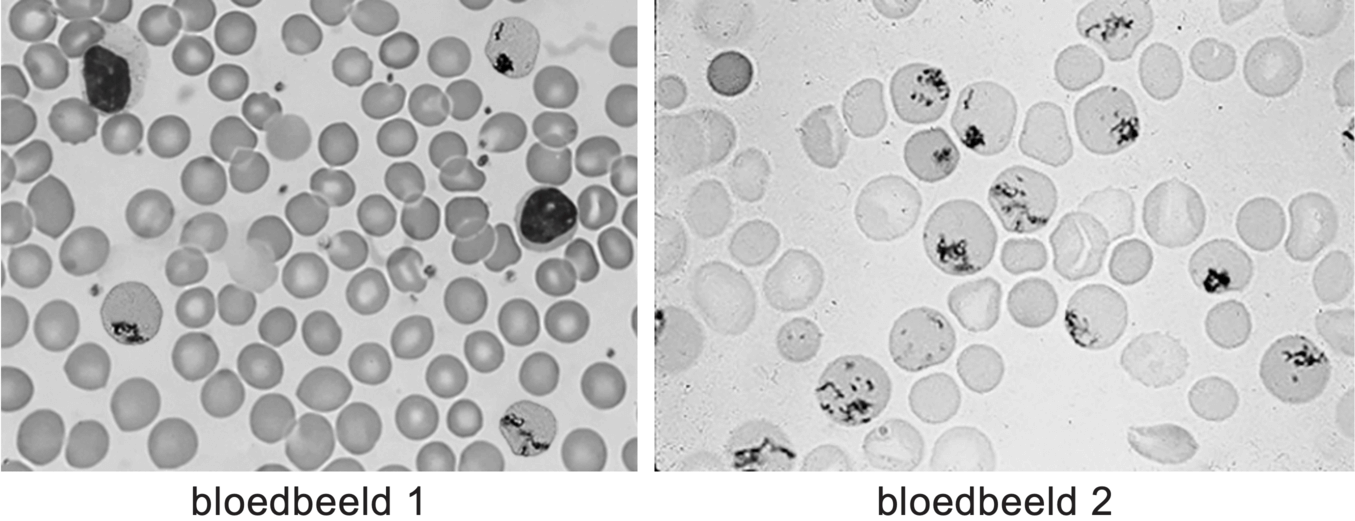
Afbeelding 2

Bij zijn geboorte leek Ryan gezond. Als het jongetje een half jaar oud is, blijkt hij echter onvoldoende gegroeid te zijn en ziet hij erg bleek.
Na bloedonderzoek blijkt Ryan de ziekte bèta-thalassemie te hebben, een erfelijke ziekte als gevolg van een mutatie in een gen voor hemoglobine. De mutatie veroorzaakt een verhoogde afbraak van rode bloedcellen. De ziekte kan worden behandeld met stamcellen uit het beenmerg van een donor.
Stamcellen uit het beenmerg doorlopen verschillende stadia voordat ze als reticulocyten in de bloedbaan komen (afbeelding 1). Vervolgens ontwikkelen ze zich daar in 24 uur tot erytrocyten: rijpe rode bloedcellen.